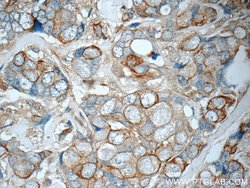
Cytokeratin 7 Rabbit anti-Human, Polyclonal, Proteintech 150 &mu;L; Unconjugated:Antibodies,
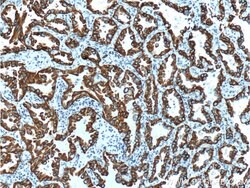
Cytokeratin 7 Rabbit anti-Human, Polyclonal, Proteintech 150 &mu;L; Unconjugated:Antibodies,

missing translation for 'onlineSavingsMsg'
Learn More
Learn More
Cytokeratin 7 Rabbit anti-Human, Polyclonal, Proteintech
Rabbit Polyclonal Antibody
Brand: Proteintech 17513-1-AP-150UL
This item is not returnable.
View return policy
Description
This antibody is specifically against KRT7.
Cytokeratin 7 blocks interferon-dependent interphase and stimulates DNA synthesis in cells. Involved in the translational regulation of the human papillomavirus type 16 E7 mRNA (HPV16 E7).Specifications
| Cytokeratin 7 | |
| Polyclonal | |
| Unconjugated | |
| KRT7 | |
| CK 7, CK7, Cytokeratin 7, K2C7, K7, keratin 7, KRT7, Sarcolectin, SCL, Type II keratin Kb7 | |
| Rabbit | |
| Antigen Affinity Chromatography | |
| RUO | |
| 3855 | |
| -20°C | |
| Liquid |
| Immunocytochemistry, Immunofluorescence, Immunohistochemistry (Paraffin), Immunoprecipitation, Western Blot | |
| 0.15 mg/mL | |
| PBS with 50% glycerol and 0.02% sodium azide; pH 7.3 | |
| P08729 | |
| KRT7 | |
| Peptide | |
| 150 μL | |
| Primary | |
| Human | |
| Antibody | |
| IgG |
Product Content Correction
Your input is important to us. Please complete this form to provide feedback related to the content on this product.
Product Title
Spot an opportunity for improvement?Share a Content Correction